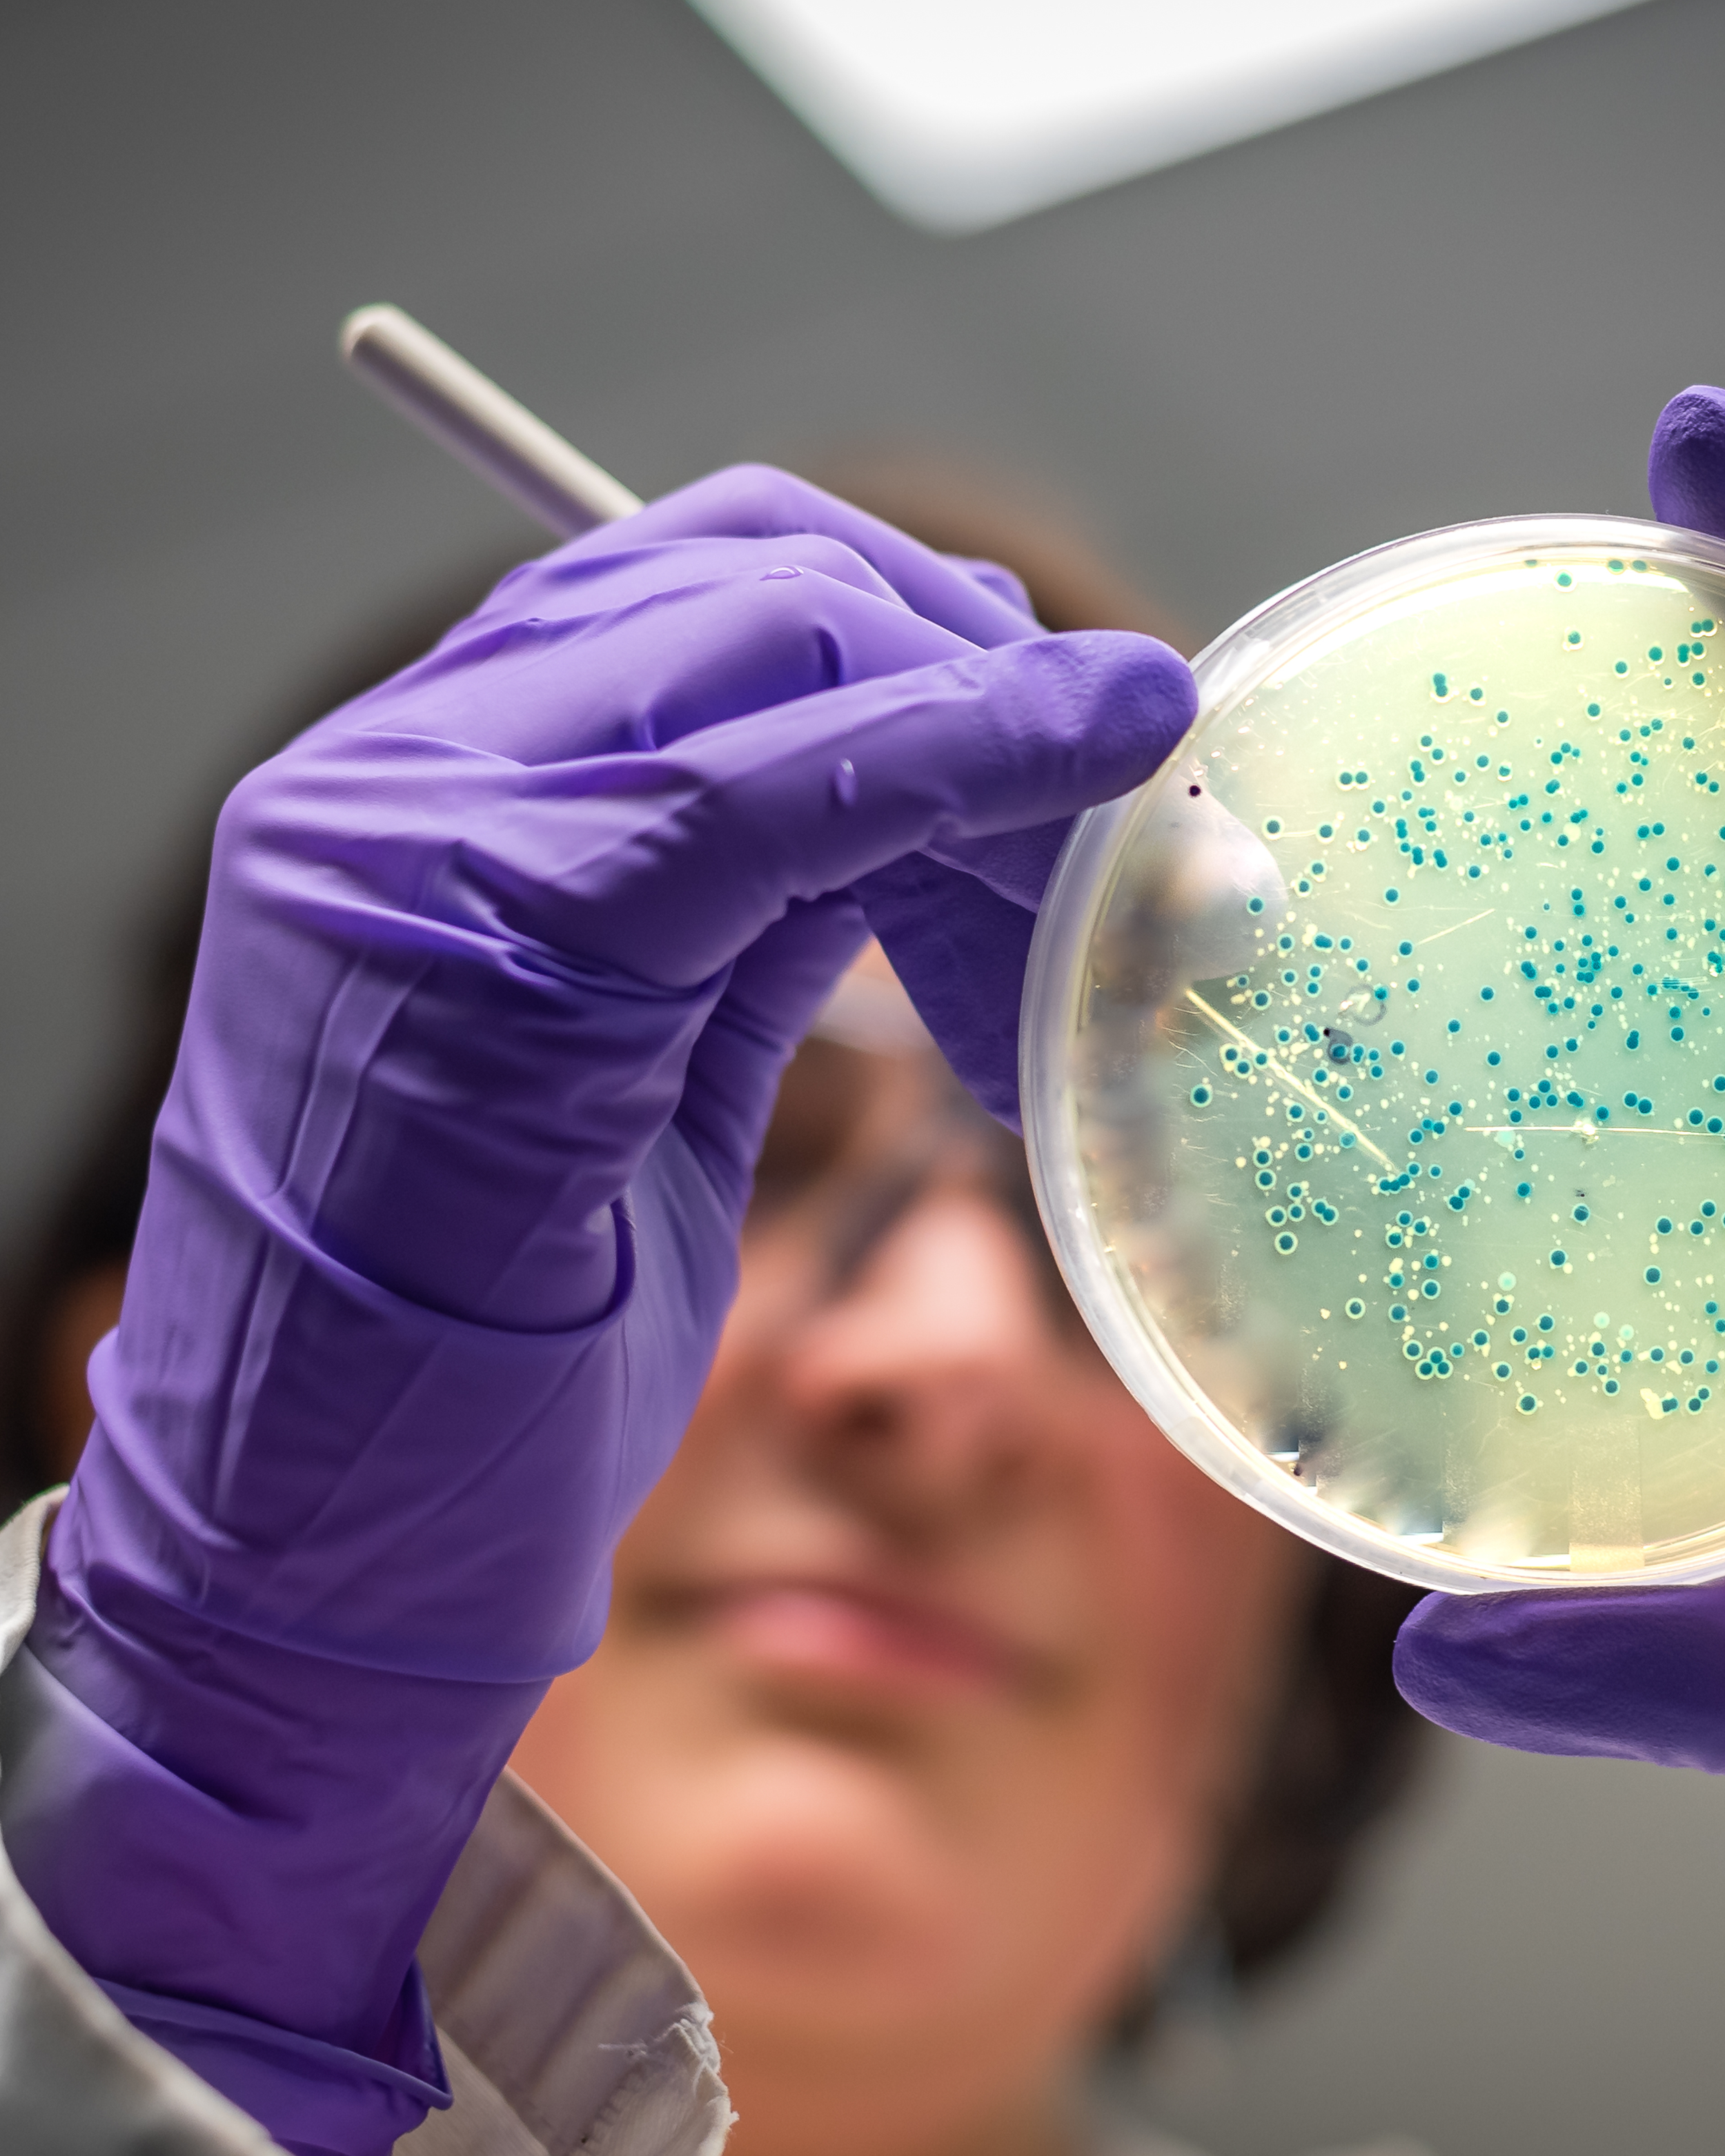

Você sabe quais vacinas podem proteger sua família contra as meningites bacterianas?
Vamos por etapas, a primeira é a vacina BCG, ela protege contra a meningite tuberculosa, esta vacina é aplica nos primeiros dias de vida.
Depois temos a vacina hexavalente, que é aplicada aos 2, 4 e 6 meses de vida e depois durante o segundo ano de vida aplicamos uma dose de reforço com a pentavalente, estas vacinas protegem contra o Haemophilus influenza do tipo b, uma bactéria capsulada que pode provocar a meningite.
Agora vamos à terceira vacina, que é a vacina contra os pneumococos, junto com a hexavalente, aplicamos a vacina conjugada pneumocócica, hoje as clínicas privadas utilizam a pneumo 20, ou seja protege contra os sorotipos mais frequentes do pneumococo que podem provocar doença pneumocócica invasiva, inclusive os 3 sorotipos mais comuns (3, 6 A e 19 A), que não estão presentes na vacina utilizada pelo SUS. E fazemos ainda um reforço da pneumocócica no segundo ano de vida para aumentar as células de memória e prolongar a proteção.
Por último temos as vacinas contra os meningococos, a vacina conjugada ACWY, aplicada aos 3 meses e 5 meses, e uma dose de reforço no segundo ano de vida, depois disso, 5 anos após este reforço, podemos e devemos aplicar um reforço a cada 5 anos, ou seja, aos 7 anos e aos 12 anos de vida, pelo menos ampliar esta proteção em pelo menos mais uma dose aos 17 anos essa vacina, além da proteção contra a invasão do agente, também tira a condição de portador dos adolescentes e adultos jovens. Este fato é importante porque estes indivíduos como são os portadores e não apresentam a doença, podem espalhar o agente entre a população, tanto das crianças menores, como dos idosos.
Esta mesma vacina pode ser utilizada em algumas situações de risco, como por exemplo, quartéis, escolas e faculdades, onde temos muitas pessoas nesta faixa etária e que podem não ter se vacinado, estando elas susceptíveis a surtos pelo convívio mais íntimo, durante um período. Exemplo clássico, algumas universidades de países como (Estados Unidos, Canadá, Australia e Europa) exigem que estes estudantes, já venham vacinados de seus países de origem, contra o meningococo ACWY, para evitar possíveis surtos.
E por último, a vacina específica contra o meningococo B, vai proteger contra este sorogrupo, por uma característica específica deste sorogrupo, a capsula que poderia ser utilizada como antígeno na vacina, não deve ser usado, porque o fator de virulência dos meningococos, ou seja, a cápsula (sorogrupo), é muito parecida com estruturas presentes quando estamos em formação durante a gestação, portanto, o nosso sistema imunológico pode não reconhecer esta estrutura como estranha, e não produzir anticorpos, ou se reconhecer, formar anticorpos contra ela, e provocar uma doença auto imune mais adiante. Então a vacina contra o meningococo B utiliza estrutura sub capsular e não a cápsula para formar os anticorpos, estas estruturas são proteínas da parede da célula do meningococo B, estas proteínas inclusive podem estar presentes em outros meningococos dos grupos A C W e Y, ajudando na proteção contra eles.
A vacina recombinante contra o meningococo B, é aplicada aos 3 e 5 meses, e um reforço no segundo ano de vida. Quem nunca tomou esta vacina, a partir dos 2 anos de idade deve se vacinar em 2 doses com intervalo de 2 meses entre as doses. Muitas universidades no exterior solicitam um reforço, antes de chegarem ao local onde estudarão, só como exemplo, no início de 2026 uma escola americana apresentou um surto de meningo B. Vale lembrar que esta vacina NÃO altera o estado de portador, isto é, a proteção é individual, quem toma a vacina, protege apenas a si mesmo, mas continua sendo um portador que pode transmitir o agente, e ocorrer a doença, depende da imunidade deste contactante.
Maiores esclarecimentos a respeito, a Immunitas vacinas está à disposição pelo site www.immunitas.com.br nas redes sociais ou pelo telefone 67 34210091, whatsapp 67 984110091, ou em nossa sede à Rua Oliveira Marques 2370, próximo ao Hospital da Vida.
Nosso horário – de segunda a sexta das 7:30 às 18:30 hs (Não fechamos para almoço) e aos sábados das 8 às 12 hs.